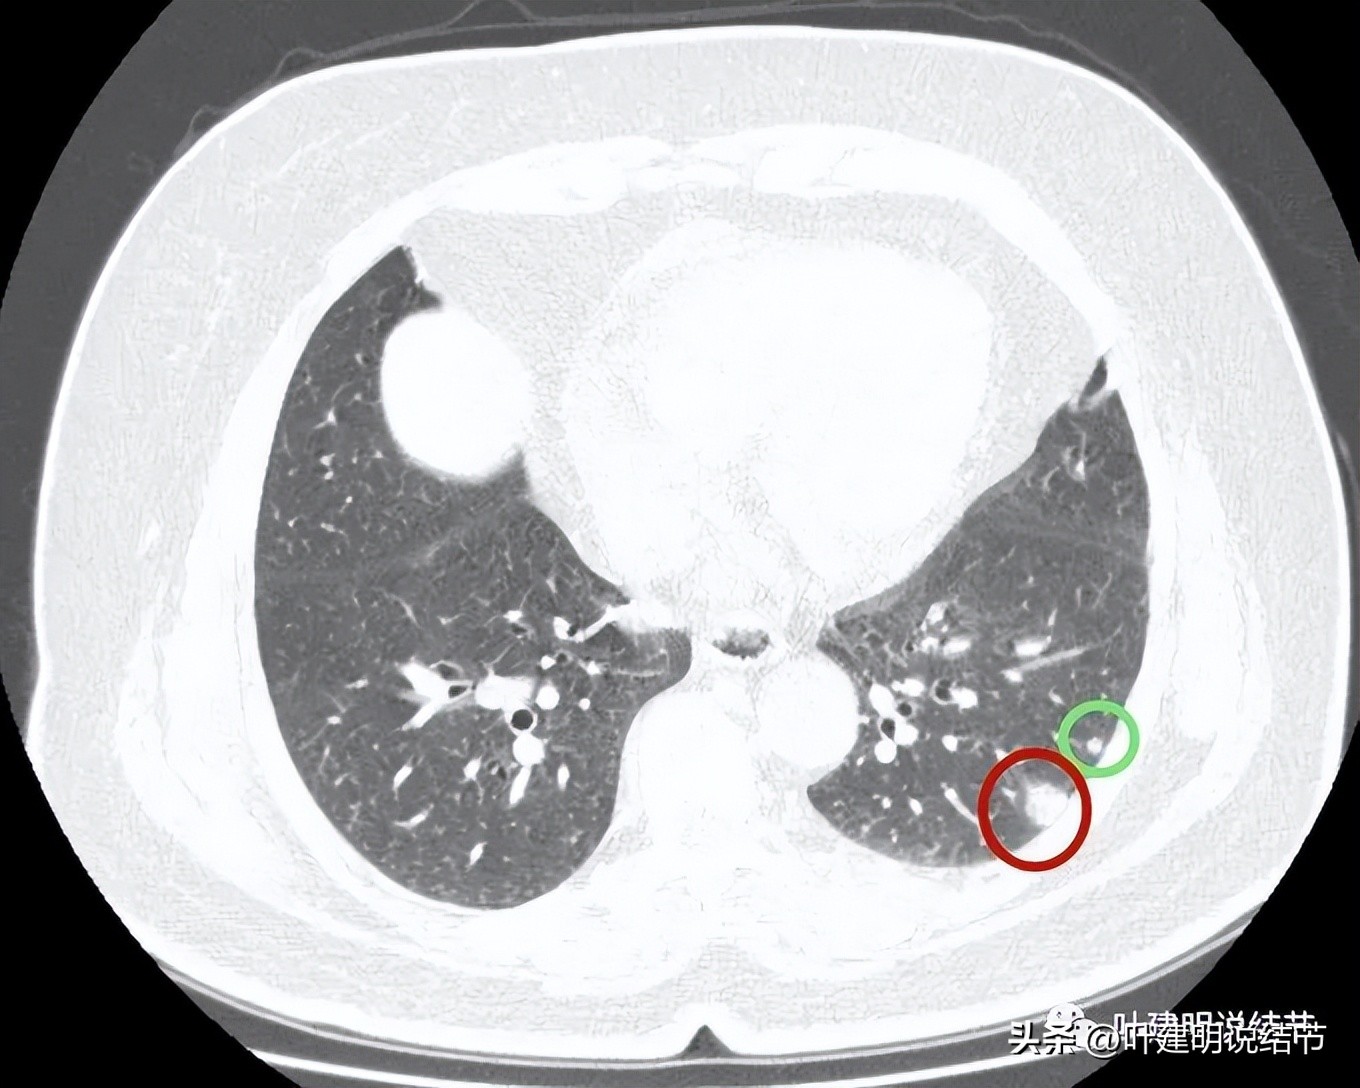
肺结节实性为什么建议抗炎治疗,肺上实性结节抗炎后变成空洞
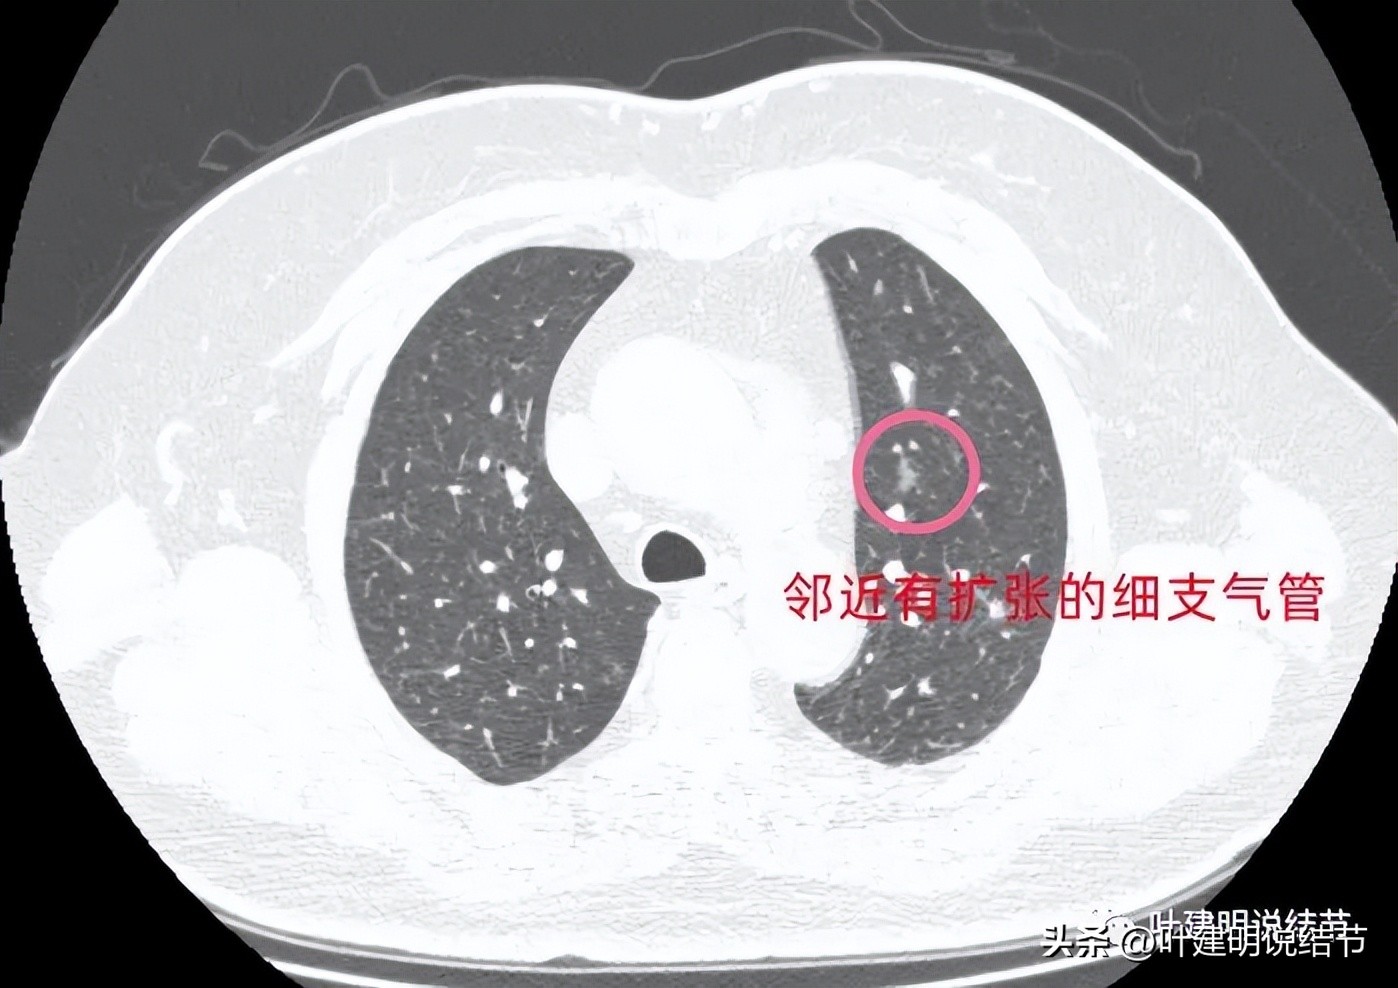
肺结节实性为什么建议抗炎治疗,肺上实性结节抗炎后变成空洞

问诊病例分享:

基本信息:
女 72岁
主诉:
发现肺结节1.5个月。
现病史:
7月中旬体检发现肺结节,输了10天消炎液,没有任何改变。8月底在某市一院复查胸部CT提示肺结节无变化。
希望获得的帮助:
请大夫给看一下严重吗?是良性还是恶性,需要手术治疗吗?
图片展示与分析:

病灶1:右上叶实性小结节,密度高,胸膜下,考虑良性可能性大

病灶2:右中叶微小实性结节,考虑纤维增生结节可能性大
病灶3:左下叶微小实性结节,边光滑,圆形,密度高,考虑良性可能性大;
病灶4:左下叶实性结节,即主病灶,实性不是很致密的病灶,胸膜下,边界较清,邻近胸膜没有牵拉。有恶性可能性(良性的用什么疾病能解释?好像错构瘤、硬化性血管瘤、结核、肉芽肿性炎、淋巴结、急性炎症、隐球菌等常见的都靠不太上)。

病灶4:见有血管进入病灶,整体上是偏实性的,但感觉不太致密
病灶5:左上叶磨玻璃影,斑片状,连续层面看邻近有扩张的细支气管。病灶轮廓较清,瘤肺边界似乎较为清楚

病灶6:左下叶背段磨玻璃结节,伴有一长毛刺,牵拉斜裂,感觉这样的病灶如果是肿瘤,收缩力太强了,不符合的,而且毛刺过长,纤细,又只有这么一根毛刺。更符合慢性炎伴纤维增生之类。

病灶7:右中叶胸膜下非圆形或类圆形高密度结节影,考虑良性。

病灶8:右上叶边缘光滑密度较高的实性微小结节,考虑良性的可能性大

病灶9:左下叶胸膜下实性微小结节,边缘光滑,密度高且均匀,考虑良性

病灶10:右下叶紧贴胸膜的扁平实性结节,考虑良性;
病灶11:胸膜下实性微小结节,与胸膜稍有粘连,但不是收缩牵拉,考虑良性结节。
我的意见:
左下叶的病灶单看真不能除外恶性,因为表面不平整,是磨玻璃偏实性的密度,整体轮廓也较清,内部密度不均,似乎还见血管征。但我们发现两肺胸膜下多发实性的微小结节,基本上都考虑是良性的,比如纤维增生结节或胶原结节可能性大,左上叶有处磨玻璃结节偏长条状,有局灶的细支气管扩张,给人的感觉是细支气管扩张伴周围慢性炎症,不是很像肿瘤。那么当两肺有这么多是炎症相关的结节时,左下主病灶会不会也是炎性的呢?显然这种概率就比较大了。其实将主病往炎性方面考虑也有许多依据的:边缘略显模糊,瘤肺边界不太清、血管进入没有增粗,也较单一;与胸膜贴近,但没有牵拉凹陷;病灶内部密度不密实,分叶或膨胀感也不明显。假如我们先撇开最后良恶性不讲,这个病灶目前应该不是典型的恶性,真恶性,也至少不是高危亚型(实体型或微乳头这种很实的密度的),大概率会是腺泡型之类,适当的随访观察应该不至于耽误病情,也不太会影响预后。所以我的想法是再过3个月复查靶扫描看看细节再说。
细节再回顾:

病灶出现,磨玻璃部分密度过低,边缘有实性成分,贴着胸膜

病灶近肺门侧有斑片状磨玻璃影(绿色箭头),病灶与胸壁间贴着,但没有牵拉(蓝色箭头),大部分是实性密度(粉色箭头)。

近肺门侧斑片影,胸膜距离近但没有牵拉;表面似乎有晕(砖色箭头)。

病灶不是很致密,中间有些偏低密度的成分,胸膜间隙征明显(按理这是肿瘤的特点,说明水肿不明显。但实性的,为什么没有牵拉?要么会是粘液腺癌吗?但粘液腺癌应该密度更均匀密实一些)。

病灶表面不是很平整,整体密度较高,胸膜间隙征存在。

病灶有血管进入,但血管是逐渐变细的,不是异常增粗。而且病灶的几条边都比较平直,缺乏膨胀性。与胸壁也是紧贴,没有造成牵拉或侵犯影响。

边缘平直,血管进入变细

边缘平直似梯形

与胸壁接触的面较宽,余边也平直。

病灶密度整体较高

边缘部分

冠状位显示病灶不是很密实,表面是不平的,但毛刺略偏长,收缩力不够

整体缺乏膨胀感

上图是矢状位的图像,感觉边缘平看,而且中间密度低于周围区域

上图靠胸壁侧似乎有毛刺,但毛刺较为模糊,而且蓝色箭头所示边缘较平直。
这个病灶确实有些四不像,但基于余肺多处病灶均考虑良性可能性大,此灶又是缺乏收缩力与膨胀性的,而且粘液腺癌似乎也不像,小细胞癌更应该不是如此表现,所以给机体一点时间,让*弹子**再飞一会儿应该更为合理。关键是我们判断它不至于是小细胞或高危亚型的浸润性腺癌。若是腺泡型,再等待一段时间应该风险也不大。当然若从抗炎无好转,病灶位置靠边,单孔局部切了化验也是可以的。

(此处已添加医疗卡片,请到*今条头日**客户端查看)